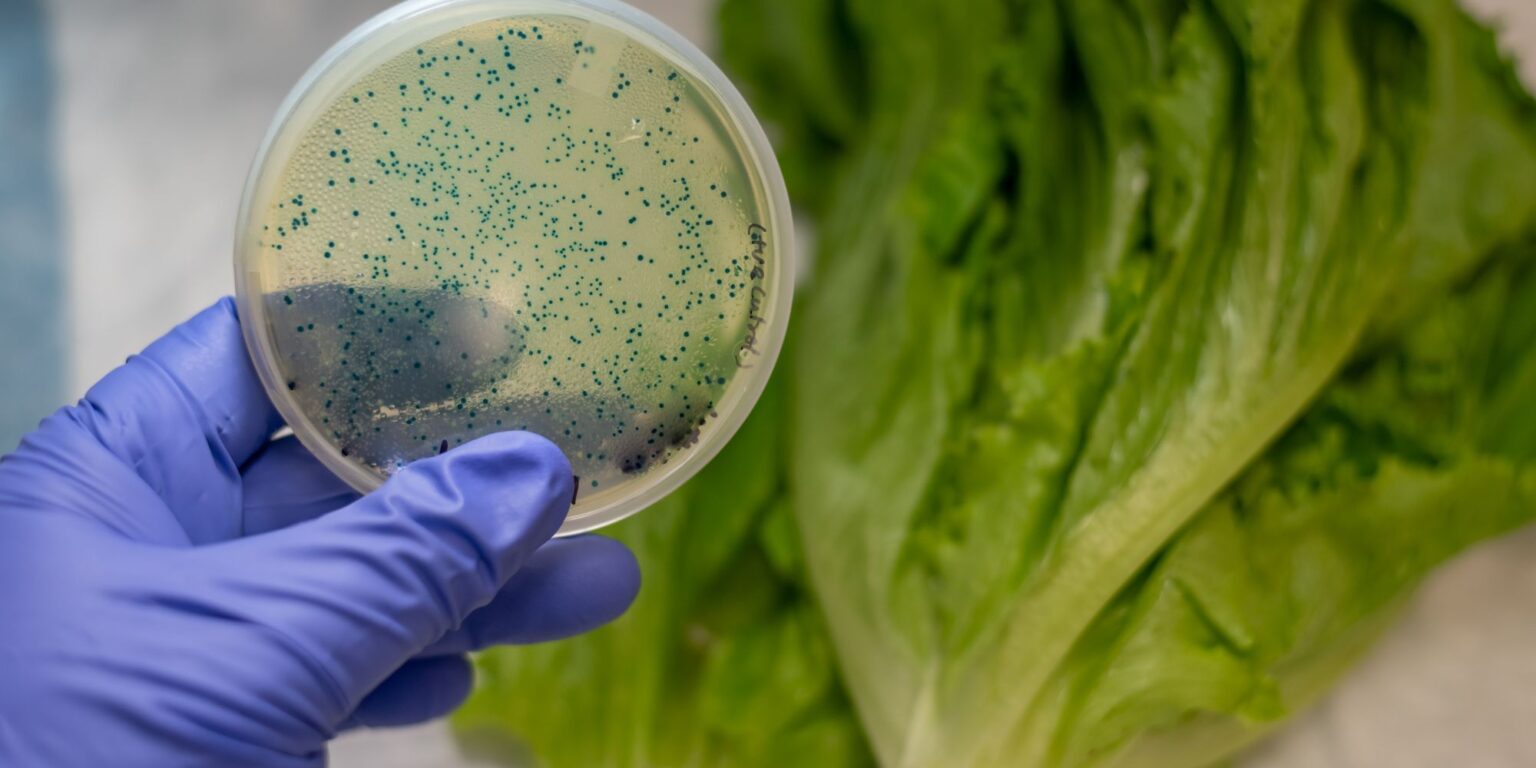

Es imprescindible siempre beber agua embotellada, sobre todo si se viaja a países de riesgo.
Las formas más directas de contagio tienen su origen en los alimentos y en el agua.
Shigella es un microorganismo bacteriano patógeno para el organismo humano. Es originario de los intestinos de los animales y muy invasivo. Su intoxicación se conoce como shigelosis, se transmite por el agua y por los alimentos y es una de las causas más frecuentes de diarreas de origen bacteriano.
Desde el punto de vista bioquímico, Shigella es un microorganismo difícil de distinguir de E. coli, Salmonella o Citrobacter spp. En cuanto a su contaminación por alimentos, es también muy similar a las otras bacterias. Como en todas, la higiene del manipulador juega un papel importante en su transmisión, aunque no es la única premisa que se debe tener en cuenta para evitar y prevenirla.
Su presencia indica una importante falta de higiene y puede transmitirse de persona a persona, a través de las manos, por el agua, por insectos o por contaminación fecal. Este artículo detalla cómo evitar Shigella de forma fácil, qué medidas deben adoptar las personas que ya tienen la bacteria y las formas de contagio.
FORMAS DE CONTAGIO
La bacteria se puede ingerir de varias maneras, aunque las más directas tienen su origen en los alimentos y en el agua. Respecto a los alimentos, la presencia de insectos como las moscas en la zona donde se manipulan favorece el contagio, ya que pueden reproducirse en excrementos infectados y, al posarse sobre la comida, contaminarla. En cuanto al agua, nadar en aguas residuales supone un riesgo, debido a la presencia de heces contaminadas, tanto de animales como de personas. Por ello, es imprescindible siempre beber agua embotellada, sobre todo si se viaja a países de riesgo.
En este último caso, hay que extremar las pautas de higiene. Shigella está presente en las heces de las personas infectadas hasta dos semanas después de su recuperación. De ahí que la mayoría de los contagios sean resultado de la bacteria, que pasa de las heces o las manos sucias de una persona a la boca de otra. Esto ocurre sobre todo cuando los hábitos de higiene básicos y lavado de las manos son ineficientes o escasos y, en especial, entre niños pequeños que no están familiarizados con la limpieza de manos y el uso del inodoro.
SÍNTOMAS DE LA «SHIGELOSIS»
Si se ingiere Shigella, su toxina penetra en la mucosa intestinal y provoca la shigelosis. Los síntomas de la enfermedad se desarrollan entre uno y tres días después de la ingestión y se inician con fiebre, dolor abdominal y diarrea acuosa. Duran entre cuatro y siete días, aunque según el tipo de cepas de la bacteria, la intoxicación puede ser mucho más grave y la duración supera los diez o doce días. Una de las características que destaca de esta contaminación es su rápida propagación, ya que la bacteria tiene una dosis infectante baja: bastan de 10 a 200 microorganismos para desatar los síntomas.
Evitar Shigella de forma fácil. PREVENCIÓN
– Lavarse las manos con jabón, antes y después de manipular alimentos. La falta de medidas higiénicas de los manipuladores es una de las causas más comunes de contaminación, por lo que es necesario un lavado a conciencia, sobre todo, en los espacios interdigitales. Una vez terminado, hay que secar con papel de un solo uso y asegurarse de que quedan bien secas. Evitar la contaminación cruzada, cuando los alimentos ya cocidos entran en contacto con los ingredientes crudos o contaminados (a través de los utensilios de cocina).
– En definitiva, una cocción adecuada y una rigurosa higiene durante la manipulación de los alimentos resulta esencial para prevenir la infección de Shigella, que se origina, en la mayoría de los casos, por la ruta oral-oral.
Qué deben evitar las personas infectadas
Las personas infectadas con la bacteria deben tener en cuenta algunos aspectos para obstaculizar la propagación de la enfermedad a personas sanas.
– Evitar trabajar en puestos cuyo riesgo de transmisión sea elevado, como locales expendedores de alimentos, cuidado de niños y ancianos o trabajadores de la industria alimentaria que estén en contacto directo con los alimentos ya procesados o pendientes de procesar.
– No manipular alimentos. Es preferible que las personas infectadas no manipulen los alimentos en ningún caso.
– Rechazar el contacto directo con niños, ancianos o personas con un sistema inmunitario deficiente, ya que en estos casos el contagio es fácil.
Fuente: https://www.consumer.es/seguridad-alimentaria/como-prevenir-shigella-en-alimentos